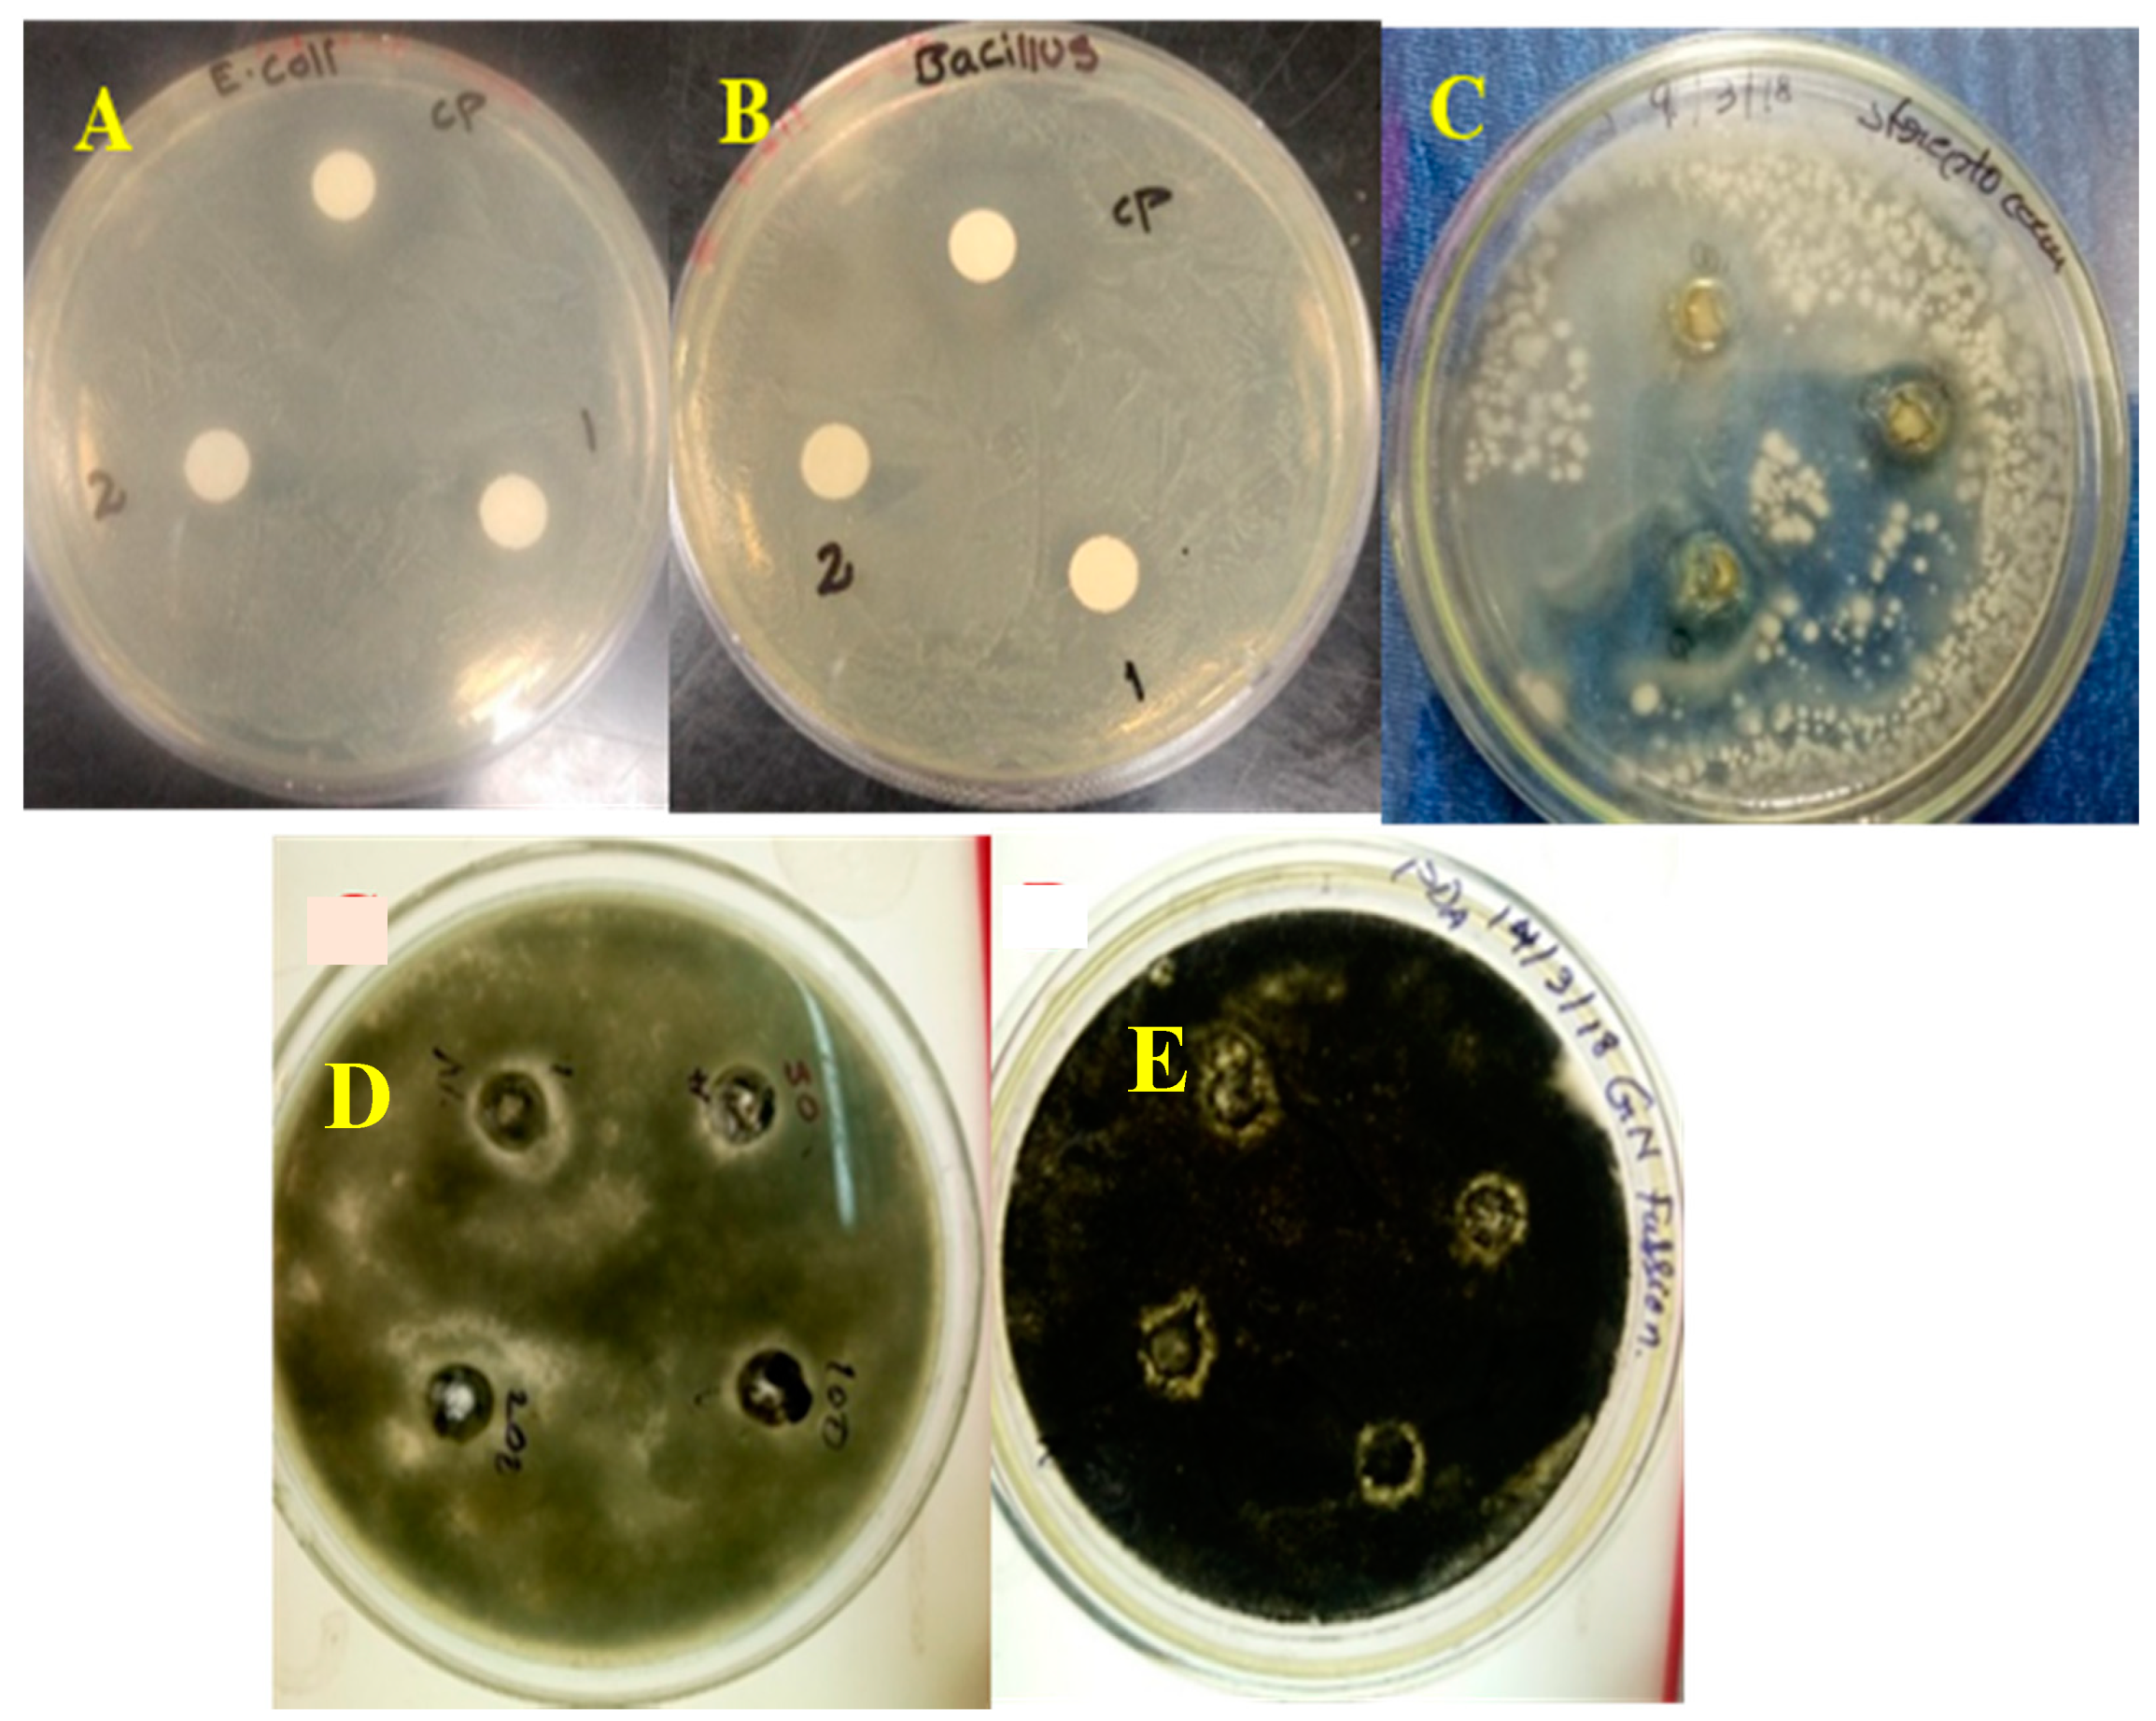

Phytogenic Generation of NiO Nanoparticles Using Stevia Leaf Extract and Evaluation of Their In-Vitro Antioxidant and Antimicrobial Properties
Abstract
1. Introduction
2. Experimental Details
2.1. Materials and Methods
Preparation of Nickel Oxide Nanoparticles Using Stevia Leaf Broth
2.2. Analytical Techniques for Analysis
2.3. Antioxidant Activity Studies
2.4. Antibacterial Activity Studies
3. Results and Discussion
3.1. UV-Vis Absorption Studies
3.2. XRD Analysis
3.3. SEM and TEM Analysis
3.4. FTIR Analysis
3.5. XPS Studies
3.6. Biological Studies: Antioxidant and Antimicrobial Activities
4. Conclusions
Supplementary Materials
Author Contributions
Funding
Acknowledgments
Conflicts of Interest
References
- Verma, R.S. Journey on greener pathways: From the use of alternate energy inputs and benign reaction media to sustainable applications of nano-catalysts in synthesis and environmental remediation. Green Chem. 2014, 16, 2027–2041. [Google Scholar] [CrossRef]
- Farran, A.; Cai, C.; Sandoval, M.; Xu, Y.; Liu, J.; Hernaiz, M.J.; Linhardt, R.J. Green solvents in carbohydrate chemistry: From raw materials to fine chemicals. Chem. Rev. 2015, 115, 6811–6853. [Google Scholar] [CrossRef] [PubMed]
- Rao, K.J.; Paria, S. Mixed phytochemicals mediated synthesis of multifunctional Ag-Au-Pd nanoparticles for glucose oxidation and antimicrobial applications. ACS Appl. Mater. Interfaces 2015, 7, 14018–14025. [Google Scholar] [CrossRef] [PubMed]
- Ezhilarasia, A.A.; Vijaya, J.J.; Kaviyarasu, K.; Kennedy, L.J.; Ramalingam, R.J.; Al-Lohedan, H.A. Green synthesis of NiO nanoparticles using Aegle marmelos leaf extract for the evaluation of in-vitro cytotoxicity, antibacterial and photocatalytic properties. J. Photochem. Photobiol. B 2018, 180, 39–50. [Google Scholar] [CrossRef]
- Toxicology and Carcinogenesis Studies of Nickel Oxide; No. 451; Department of Health and Human Services, National Institute of Health: Bethesda, MD, USA, 1996.
- English, J.C.; Parker, R.D.R.; Sharma, R.P.; Oberg, S.G. Toxicokinetics of nickel in rats after intratracheal administration of a soluble and insoluble form. Am. Ind. Hyg. Assoc. J. 1981, 42, 486–492. [Google Scholar] [CrossRef]
- Benson, J.M.; Barr, E.B.; Bechtold, W.E.; Cheng, Y.-S.; Dunnick, J.K.; Eastin, W.E.; Hobbs, C.H.; Kennedy, C.H.; Maples, K.R. Fate of inhaled nickel oxide and nickel subsulfie in F344/N rats. Inhal. Toxicol. 1994, 6, 167–183. [Google Scholar] [CrossRef]
- Du, Y.; Wang, W.; Li, X.; Zhao, J.; Ma, J.; Liu, Y.; Lu, G. Preparation of NiO nanoparticles in microemulsion and its gas sensing performance. Mater. Lett. 2012, 68, 168–170. [Google Scholar] [CrossRef]
- Wang, W.N.; Itoh, Y.; Lenggoro, I.W.; Okuyama, K. Nickel and nickel oxide nanoparticles prepared from nickel nitrate hexahydrate by a low pressure spray pyrolysis. Mater. Sci. Eng. B 2004, 111, 69–76. [Google Scholar] [CrossRef]
- Fereshteh, Z.; Salavati-Niasari, M.; Saberyan, K.; Hosseinpour-Mashkani, S.M.; Tavakoli, F. Synthesis of nickel oxide nanoparticles from thermal decomposition of a new precursor. J. Clust. Sci. 2012, 23, 577–583. [Google Scholar] [CrossRef]
- Ahmadisoltansaraei, K.; Moghaddam, J. Preparation of NiO nanoparticles from Ni(OH)2 NiCO34H2O precursor by mechanical activation. Int. J. Miner. Metall. Mater. 2014, 21, 726–735. [Google Scholar] [CrossRef]
- Alagiri, M.; Ponnusamy, S.; Muthamizhchelvan, C. Synthesis and characterization of NiO nanoparticles by solegel method. J. Mater. Sci. Mater. Electron. 2012, 23, 728–732. [Google Scholar] [CrossRef]
- Kalam, A.; Al-Sehemi, A.G.; Al-Shihri, A.S.; Du, G.; Ahmad, T. Synthesis and characterization of NiO nanoparticles by thermal decomposition of nickel linoleate and their optical properties. Mater. Charact. 2012, 68, 77–81. [Google Scholar] [CrossRef]
- Lai, T.L.; Shu, Y.-Y.; Huang, G.-L.; Lee, C.-C.; Wang, C.-B. Microwave-assisted and liquid oxidation combination techniques for the preparation of nickel oxide nanoparticles. J. Alloys Compd. 2008, 450, 318–322. [Google Scholar] [CrossRef]
- Helan, V.; Joseph Prince, J.; Al-Dhabi, N.A.; Valan Arasu, M.; Ayeshamariam, A.; Madhumitha, G.; Roopan, S.M.; Jayachandran, M. Neem leaves mediated preparation of NiO nanoparticles and its magnetization, coercivity and antibacterial analysis. Results Phys. 2016, 6, 712–718. [Google Scholar] [CrossRef]
- Dina, M.I.; Nabia, A.G.; Rania, A.; Aihetasham, A.; Mukhtar, M. Single step green synthesis of stable nickel and nickel oxide nanoparticles from Calotropis gigantea: Catalytic and antimicrobial potentials. Environ. Nanotechnol. Monitor. Manag. 2018, 9, 29–36. [Google Scholar] [CrossRef]
- Thema, F.T.; Manikandan, E.; Gurib-Fakim, A.; Maaza, M. Single phase Bunsenite NiO nanoparticles green synthesis by Agathosma betulina natural extract. J. Alloys Compd. 2016, 657, 655–661. [Google Scholar] [CrossRef]
- Helen, S.M.; Rani, H.E. Characterization and antimicrobial study of nickel nanoparticles synthesized from Dioscorea (elephant yam) by green route. Int. J. Sci. Res. 2015, 4, 216–219. [Google Scholar]
- Kaushik, R.; Pradeep, N.; Vamshi, V.; Geetha, M.; Usha, A. Nutrient composition of cultivated stevia leaves and the infl uence of polyphenols and plant pigments on sensory and antioxidant properties of leaf extracts. J. Food Sci. Technol. 2010, 47, 27–33. [Google Scholar] [CrossRef]
- Savita, S.M.; Sheela, K.; Sharan, S.; Shankar, A.G.; Ramakrishna, P. Stevia rebaudiana—A functional component for food industry. J. Hum. Ecol. 2004, 15, 261–264. [Google Scholar] [CrossRef]
- Geuns, J.M.C. Molecules of interest: Stevioside. Phytochemistry 2003, 64, 913–992. [Google Scholar] [CrossRef]
- Laguta, I.; Stavinskaya, O.; Kazakova, O.; Fesenko, T.; Brychka, S. Green synthesis of silver nanoparticles using Stevia leaves extracts. Appl. Nanosci. 2019, 9, 755–765. [Google Scholar] [CrossRef]
- Sadeghi, B.; Mohammadzadeh, M.; Babakhani, B. Green synthesis of gold nanoparticles using Stevia rebaudiana leaf extracts: Characterization and their stability. J. Photochem. Photobiol. B 2015, 148, 101–106. [Google Scholar] [CrossRef] [PubMed]
- Mallikarjuna, K.; Raju, B.D.P.; Kim, H.S. Sustainable fabrication of palladium nanoparticles using stevia rebaudiana tea and its catalytic activity. J. Nanosci. Nanotechnol. 2017, 17, 4251–4256. [Google Scholar] [CrossRef]
- Brand-Williams, W.; Cuvelier, M.E.; Berset, C. Use of free radical method to evaluate antioxidant activity. Lebens Wisstechnol. 1995, 28, 25–30. [Google Scholar] [CrossRef]
- Mallikarjuna, K.; Kotesh Kumar, M.; Subba Reddy, B.V.; Kim, H. Hydrogen Production from Water Splitting: Fabrication of ZnO Nanorod Decorated Cu NW Heterogeneous Hybrid Structures for Photocatalytic Applications. J. Clust. Sci. 2019, 30, 449–457. [Google Scholar] [CrossRef]
- Bashir, A.K.H.; Razanamahandry, L.C.; Nwanya, A.C.; Kaviyarasu, K.; Saban, W.; Mohamed, H.E.A.; Ntwampe, S.K.O.; Ezema, F.I.; Maaza, M. Biosynthesis of NiO nanoparticles for photodegradation of free cyanide solutions under ultraviolet light. J. Phys. Chem. Solids 2019, 134, 133–140. [Google Scholar] [CrossRef]
- Mallikarjuna, K.; Kim, H. Synthesis and characterization of highly active Cu/Pd bimetallic nanostructures. Collod. Surf. A 2017, 535, 194–200. [Google Scholar] [CrossRef]
- Yamamoto, O. Influence of particle size on the antibacterial activity of zinc oxide. Int. J. Inorg. Mater. 2001, 3, 643–646. [Google Scholar] [CrossRef]
- Muhammad, A.R.; Zakia, K.; Anum, R.; Anjum, N.S.; Saira, R.; Shahzad, N. Size- and Shape-Dependent Antibacterial Studies of Silver Nanoparticles Synthesized by Wet Chemical Routes. Nanomaterials 2016, 6, 74. [Google Scholar]
- Anon. 2019. Available online: https://pdfs.semanticscholar.org/2a3a/79569ca1c01ae66191f1d83251fde57c0ead.pd (accessed on 19 December 2019).
- Tavakoli, S.; Kharaziha, M.; Ahmadi, S. Green Synthesis and Morphology Dependent Antibacterial Activity of Copper Oxide Nanoparticles. J. Nanostruct. 2019, 9, 163–171. [Google Scholar]
- Saleem, S.; Ahmed, B.; Khan, M.S.; Al-Shaeri, M.; Musarrat, J. Inhibition of growth and biofilm formation of clinical bacterial isolates by NiO nanoparticles synthesized from Eucalyptus globulus plants. Microb. Pathogen. 2017, 111, 375–387. [Google Scholar] [CrossRef] [PubMed]
- Mayedwa, N.; Mongwaketsi, N.; Khamlich, S.; Kaviyarasu, K.; Matinise, N.; Maaza, M. Green synthesis of nickel oxide, palladium and palladium oxide synthesized via Aspalathus linearis natural extracts: Physical properties & mechanism of formation. Appl. Surf. Sci. 2018, 446, 266–272. [Google Scholar]
- Rong, X.; Qiu, F.; Qin, J.; Zhao, H.; Yan, J.; Yang, D. A facile hydrothermal synthesis, adsorption kinetics and isotherms to Congo Red azo-dye from aqueous solution of NiO/graphene nanosheets adsorbent. J. Ind. Eng. Chem. 2015, 26, 354–363. [Google Scholar] [CrossRef]
- Ejidike, I.P.; Ajibade, P.A. Synthesis, spectroscopic, antibacterial and free radical scavenging studies of Cu(II), Ni(II), Zn(II) and Co(II) complexes of 4,4′-{ethane-1,2-diylbis[nitrilo(1E)eth-1-yl-1- ylidene]}dibenzene-1,3-diol Schiff base. J. Pharm. Sci. Res. 2017, 9, 593–600. [Google Scholar]
- Arokiyaraj, S.; Arasu, M.V.; Vincent, S.; Prakash, N.U.; Choi, S.H.; Oh, Y.K.; Choi, K.C.; Kim, K.H. Rapid green synthesis of silver nanoparticles from Chrysanthemum indicum L. and its antibacterial and cytotoxic effects: An in vitro study. Int. J. Nanomed. 2014, 9, 379. [Google Scholar] [CrossRef]
- Basak, G.; Das, D.; Das, N. Dual role of acidic diacetate sophorolipid as biostabilizer for ZnO nanoparticle synthesis and biofunctionalizing agent against Salmonella enterica and Candida albicans. J. Microbiol. Biotechnol. 2014, 24, 87–96. [Google Scholar] [CrossRef]
- Jesudoss, S.K.; Vijaya, J.J.; Clament, N.; Selvam, S.; Kombaiah, K.; Sivachidambaram, M.; Adinaveen, T.; Kennedy, L.J. Effects of Ba doping on structural, morphological, optical, and photocatalytic properties of self-assembled ZnO nanosphere. Clean Technol. Environ. Policy 2016, 18, 729–741. [Google Scholar] [CrossRef]

| Compd. | Zone of Inhibition (mm) | ||||
|---|---|---|---|---|---|
| E. coli | B. subtilis | S. pneumonia | A. niger | A. fumigatus | |
| NiO | 16 | 12 | 14 | 6 | 4 |
| Ni(OH)2 | 20 | 10 | 16 | 8 | 6 |
| Chloramphenicol | 28 | 26 | 20 | 12 | 10 |
© 2020 by the authors. Licensee MDPI, Basel, Switzerland. This article is an open access article distributed under the terms and conditions of the Creative Commons Attribution (CC BY) license (http://creativecommons.org/licenses/by/4.0/).
Share and Cite
Srihasam, S.; Thyagarajan, K.; Korivi, M.; Lebaka, V.R.; Mallem, S.P.R. Phytogenic Generation of NiO Nanoparticles Using Stevia Leaf Extract and Evaluation of Their In-Vitro Antioxidant and Antimicrobial Properties. Biomolecules 2020, 10, 89. https://doi.org/10.3390/biom10010089
Srihasam S, Thyagarajan K, Korivi M, Lebaka VR, Mallem SPR. Phytogenic Generation of NiO Nanoparticles Using Stevia Leaf Extract and Evaluation of Their In-Vitro Antioxidant and Antimicrobial Properties. Biomolecules. 2020; 10(1):89. https://doi.org/10.3390/biom10010089
Chicago/Turabian StyleSrihasam, Saiganesh, Krishnan Thyagarajan, Mallikarjuna Korivi, Veeranjaneya Reddy Lebaka, and Siva Pratap Reddy Mallem. 2020. "Phytogenic Generation of NiO Nanoparticles Using Stevia Leaf Extract and Evaluation of Their In-Vitro Antioxidant and Antimicrobial Properties" Biomolecules 10, no. 1: 89. https://doi.org/10.3390/biom10010089
APA StyleSrihasam, S., Thyagarajan, K., Korivi, M., Lebaka, V. R., & Mallem, S. P. R. (2020). Phytogenic Generation of NiO Nanoparticles Using Stevia Leaf Extract and Evaluation of Their In-Vitro Antioxidant and Antimicrobial Properties. Biomolecules, 10(1), 89. https://doi.org/10.3390/biom10010089

